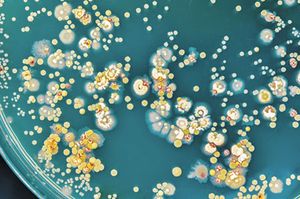

One manager needs to know whats required in her veterinary practice safety plan, especially with her regions biggest risk of natural disaster.

Katie Adams, CVPM, is owner and management consultant at Agrygation Consulting.

One manager needs to know whats required in her veterinary practice safety plan, especially with her regions biggest risk of natural disaster.

When a veterinary team member messes up left and right, but is still looked upon through rose-colored glasses by doctors and managers, what can be done?

What do I do with a veterinary technician undermining her coworkers?

Yes. Youre helping the veterinary hospital by getting rid of the toxic team member who brings down the whole veterinary team and sucks the air out of the room.

In a change this large, communication and feedback are key to keep everyone on the veterinary team feeling comfortable, says Katie Adams, CVPM.

Hes a great team member at the veterinary hospital, but occasional body odor could become a problem. I say dont be afraid to talk about it directly, privately and kindly.

Ah, the hospital workplace romance. So achingly cute! So wildly entertaining! So Greys Anatomy! Now add puppies, kittens and a veterinary team. Impossibly adorable, right?

What can you do when the practice owners niece doesnt pull her weight? Anything?

An ownership change causes growing pains.

You know the scenarios and the characters, now just act them out using this framework

The veterinary staff at this practice get the job done just not the way theyd been trained to. In cases like this, training and re-training might not be the answer.

Youve changed things this year in your veterinary practice? Human beings are resistant to change, and your veterinary team members are human beings. Here are some basic steps to face this.

Hit one of the three Rs of retention, says Katie Adams, CVPM.

Checking in every six months, in a 360-degree format is what Katie Adams, CVPM, favors.

Dont beat up on yourself, folks. Just because a new job at a veterinary practice sounded good, and you were hired, doesnt mean its a good fit for you.

Millennials have grown up with technology and the conveniences it affords. If veterinary practices dont adapt to their expectations, they risk being replaced.

A bitter problem, but a sweet solution! If youre managing hospital inventory costs and you need a solid benchmark to use, consider COGS.

Give it to me straight, says one reader to our CVPM advice guru: Are veterinary wellness plans worth the time?

Wheres the jumping off point for jumping into veterinary team building activities? Here are a few of my favorite resources.

Dont judge potential veterinary hires based on application alone. Our management expert Katie Adams, CVPM, says your impression during the in-person interview matters more.

Otitis cases may need more than one appointment to resolve, but how do you get clients to see the importance of bringing their pet back to the clinic?

This readers hospital has a generous employee discount on products and services, so some veterinary team members seem to be loading up on pets. Our certified veterinary practice manager Katie Adams says its time to rein in the rewards.

When veterinary team members are shirking their duties and there isnt exactly a line of applicants willing to replace them, what are you to do? Our practice management expert Katie Adams, CVPM, has answers.

Warnings wont cut it, says resident CVPM advice guru Katie Adams. Creating an improvement plan with coaching sessions is crucial if youre not ready to fire the toxic veterinary team member.

If motivating your team to stay engaged with the veterinary profession both inside and outside your practice walls is giving you grief, Katie Adams, CVPM, has a plan to replace your tears with tiers.

Katie Adams, CVPM, counsels a veterinary team member concerned about threats to the practice's pharmacy business.

Whether you have a positive or negative culture at your veterinary practice may be traced back to how closely youre sticking to your core values.

Our resident veterinary practice management expert Katie Adams, CVPM, counsels a new practice owner on how to handle an overpaid and ineffective employee.

This business acronym is a crucial metric for every veterinary practice owner or manager.

Let's face it: You want potential employees to swipe right. Here's how to make your veterinary clinic more attractive when it comes to hiring and orientation.

Published: February 7th 2018 | Updated:

Published: February 15th 2018 | Updated:

Published: March 20th 2018 | Updated:

Published: April 19th 2018 | Updated:

Published: May 15th 2018 | Updated:
Published: May 17th 2018 | Updated: